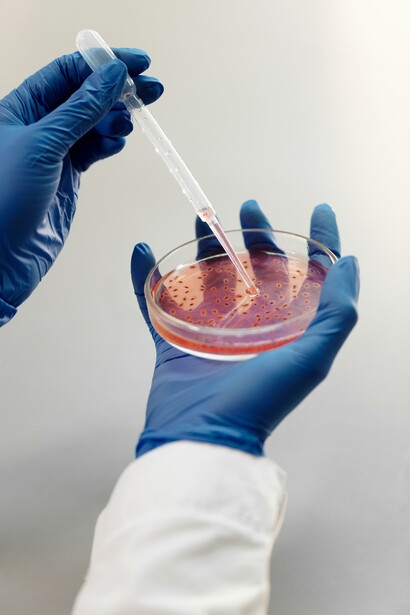
A irradiação contribui para uma grade economia pois diminui a incidência doenças de origem alimentares, que levam à perdas financeiras de cerca de 6.9 bilhões de dólares anuais nos Estados Unidos

Em 1895, o físico alemão Wilhelm Rötinger descobriu o raio-x. Esta descoberta e a discussão sobre a interferência das substâncias na produção desses raios estimularam os estudos de Henry Becquerel sobre as radiações ultravioleta, a fluorescência e a fosforescência, que acabaram por levá-lo à descoberta da radioatividade. Ele suspeitou que essa radiação se originava da própria substância que ele estudava à época, o sal de urânio. Essa suspeita foi confirmada em 1897 pelo casal Curie. Inclusive, o nome radioatividade foi atribuído por Marie Curie tendo em vista que as substâncias que estudavam, o tório, o urânio e o polônio, emitiam radiação espontânea de forma semelhante ao elemento rádio.
A origem da radioatividade encontra-se no núcleo atômico. Este núcleo é formado por prótons, partículas com carga elétrica positiva e que, naturalmente, deveriam se repelir, e nêutrons, partículas eletricamente neutras. O equilíbrio deste núcleo é mantido por meio de uma interação conhecida por força forte, um tipo de interação de grande intensidade e curto alcance. No entanto, alguns elementos possuem isótopos (elementos com o mesmo número de prótons no núcleo mas diferente número de nêutrons) que são instáveis. Para tornar este núcleo mais estável, ele precisa diminuir sua energia, o que faz emitindo radiação.
Existem, basicamente, três tipos de radiação de origem nuclear: partículas alfa, partículas beta e radiação gama. Partículas alfa correspondem a núcleos do elemento hélio. São partículas de grande massa de energia, porém, de curto poder de penetração. As partículas beta correspondem a elétrons ou pósitrons (elétrons de carga positiva). Possuem massa menor que as partículas alfa e, portanto, maior poder de penetração. E a radiação gama, que consiste em radiação eletromagnética de altíssima energia e grande poder de penetração. Desde sua descoberta, foram desenvolvidas diferentes formas de aplicação para essas radiações nucleares, entre elas, a que iremos destacar, a irradiação de alimentos. Logo, menos resistentes ao calor, sendo eliminados durante a preparação dos alimentos.
O primeiro registro do uso de radiação em alimentos remonta ao ano de 1905, quando a técnica foi utilizada em carne de porco cuja finalidade era eliminar a tênia solium, também conhecida como solitária, responsável por doenças intestinais. Hoje em dia, sua aplicação é muito mais vasta, contribuindo para o combate de enfermidades de origem alimentar, provocadas por microrganismos patogênicos como a salmonella. Os principais isótopos usados no processo são o cobalto-60 (lê-se cobalto sessenta) e o césio-137, as fontes usadas em dispositivos conhecidos como irradiadores.
Um irradiador é composto de três partes: a blindagem, uma grade contendo a fonte do composto radioativo e um dispositivo para expor as fontes. Antes da exposição dos alimentos, as grades contendo as fontes se encontram no fundo de um tanque entre 4 e 7 metros de profundidade, cheios de água que tem como finalidade servir como blindagem, evitar a presença de seres humanos próximos das fontes e para dissipar o possível calor dissipado pela fonte. O tanque é formado por paredes de concreto com cerca de dois metros de expessura, para atenuar os níveis de radiação provenientes das grades.
Os alimentos são transportados em caixas, através de esteiras, até a região de exposição no momento em que a grade contendo as fontes é suspensa por meio de um dispositivo próprio. Os alimentos recebem a radiação por um tempo que depende da dosagem a ser administrada. Essa dosagem, por sua vez, depende do tipo de material a ser irradiado e do objetivo da utilização da técnica. Por exemplo, para a eliminação da salmonella em carne de frango, são aplicadas dosagens de 3.0 kGy (kilo-grey, unidade de dosagem de radiação), eliminando até 99% dos microrganismos. Dosagens entre 0,05 e 0,15 kGy, são utilizadas para evitar o brotamento em alimentos como batata, inhame, cebolha e alho.
O processo de irradiação elimina organismos patogênicos da seguinte forma: ao interagir com a matéria biológica, a radiação gama proveniente das fontes de cobalto-60, provoca danos na estrutura do material irradiado, que pode ser de forma direta e indireta. No primeiro caso, a radiação danifica a estrutura dos ácidos nucleicos, DNA e RNA, inibindo a reprodução celular, inserindo erros que impedem a sua transcrição, comprometendo a funcionalidade celular e, por fim, a sua morte. Os danos indiretos, por outro lado, são provenientes da interação entre a radiação e a água existente no interior celular. As moléculas de água são quebradas produzindo os radicais livres, OH- e H+. Esses radicais livres interagem entre si formando água novamente, ou o composto H2 O2, peróxido de hidrogênio, que é tóxico, conduzindo, também, à morte celular.
Como dito, a irradiação pode ainda ser utilizada para adiar o brotamento em vegetais. Ao fim do período de dormência, o vegetal passa por um período de intensa divisão celular e alongamento dos meristemas, pontos de crescimentos dos vegetais. A irradiação no período de dormência inibe a síntese de ácidos nucleicos e nucleotídeos do tecido meristemático e altera a síntese das auxinas, hormônio do crescimento, comprometendo a divisão celular. Como consequência, o amadurecimento do vegetal torna-se mais lento, estendendo a sua vida útil.
Para compreendermos a importância da irradiação de alimentos, precisamos conhecer um pouco dos males causados por alimentos contaminados. Doenças de origem alimentar afligem milhões de pessoas todos os anos ao redor do mundo. Como exemplo, a salmonella, responsável pela gastroenterite, atinge cerca de 1,5 milhão de pessoas todos os anos apenas nos Estados Unidos. Embora o número de vítimas fatais seja relativamente pequeno, são comuns, para essa enfermidade, internações hospitalares, contribuindo para ausências no trabalho, resultando em profundas perdas do ponto de vista econômico, estimadas em cerca de 2,4 bilhões de dólares anuais. Na verdade, todas as doenças de origem alimentares levam à perdas financeiras de cerca de 6.9 bilhões de dólares anuais nos Estados Unidos. Tendo em vista a sua enorme capacidade de eliminar microrganismos presentes em alimentos, a irradiação contribui para uma grade economia, tanto por reduzir o número de internações hospitalares quanto pela redução da perda de capacidade produtiva por conta dos trabalhadores contaminados.
Outro impacto econômico relevante vem da extensão da vida útil de alimentos irradiados, especialmente os de origem vegetal. Batatas irradiada possuem durabilidade de até seis meses contra um mês das não-irradiadas. Morangos não irradiados possuem vida útil de cerca de sete dias. Já a versão sujeita a radiação dura cerca de vinte e um dias. A extensão da vida útil de alimentos contribui para economia do produtor ao consumidor final, uma vez que há um menor desperdício de alimentos.
Apesar destas vantagens apresentadas, a irradiação ainda enfrenta inúmeros desafios para a sua aceitação pela sociedade em decorrência do preconceito generalizado contra o uso da energia nuclear.
Uma das principais preocupações sobre a irradiação de alimentos é de que dosagens insuficientes para eliminar os microrganismos poderiam catalisar mutações que levariam a produção de micróbios ainda mais perigosos. No entanto, até o presente, não se encontrou evidências que justifiquem tal temor. Na realidade, o que se verificou foi que os micróbios que resistem a radiação são, por outro lado, menos resistentes ao calor, sendo eliminados durante o processo de preparação dos alimentos.
Outro motivo de temor são os produtos radiolíticos produzidos pela radiação. Ao interagir com a matéria, a radiação pode quebrar as ligações presentes em moléculas como as de água e proteínas, gerando radicais livres que interagem, recombinando com outros produtos químicos. Esses compostos resultantes poderiam, segundo se especula, ser cancerígenos. No entanto, os produtos radiolíticos encontrados em alimentos irradiados são encontrados naturalmente em alimentos não-irradiados e a sua concentração tem se mostrado insignificante. O maior problema encontrado nestes produtos radiolíticos são as alterações provocadas na cor, textura e odor dos alimentos, tornando-os indesejados para certas aplicações culinárias. Batatas irradiadas, por exemplo, não se mostram apropriadas para a preparação de chips, uma vez que não se consegue prover uma textura crocante. No entanto, não foram encontradas evidências de que estes produtos provoquem danos à saúde.
Há ainda a crença de que a irradiação pode comprometer a qualidade nutricional dos alimentos. É verdade que foi observada uma redução de micronutrientes em alguns alimentos como a carne bovina, que apresenta uma menor concentração de vitamina B do que sua versão não irradiada. Porém, esta redução em valores médios somente comprometeria a qualidade da alimentação em casos extremos de deficiência alimentar, o que faz com que seja considerada uma consequência de baixo risco, já que poderiam ser supridas por meio de uma dieta diversificada. Além disso, as alterações nas concentrações de nutrientes não são maiores do que as encontradas em outras formas de preparação de alimentos, como o cozimento.
Como pode-se notar, o processo de irradiação de alimentos pode provocar impactos extremamente positivos para a sociedade, contribuindo para diminuir a incidência de doenças de origem alimentar, reduzindo o número de mortes e internações. Pode ainda provocar um impacto econômico positivo, reduzindo os custos com internações hospitalares e com a perda da força produtiva devido às doenças. Pode ainda contribuir positivamente com o aumento da vida útil de alimentos e, assim, aumentando a sua disponibilidade.
Obviamente, a ciência encontra-se em constante construção, o que implica que é necessário mais pesquisas para que se possa compreender plenamente as consequências de sua utilização. É preciso, também, que haja uma maior publicidade, a fim de se desfazer o preconceito quanto a esta prática, o que passa por um ensino mais efetivo sobre os usos da energia nuclear, em especial durante o ensino médio brasileiro.